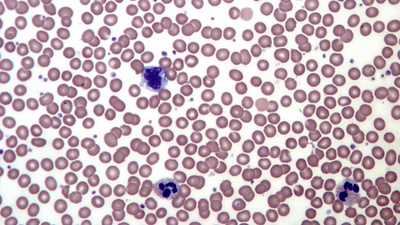

Priponka 'T49.jpg'
Prenesi na svoj računalnik
Pripete datoteke
Za sklic na priponko uporabite obliko attachment:filename, kot je prikazano spodaj v seznamu datotek. NE UPORABLJAJTE URL-ja povezave ob [get], oblika tega URL-ja se namreč lahko kadarkoli spremeni in povezava bo tako prekinjena.Tej strani ne smete dodati priponk.
